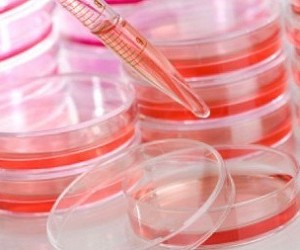

Характеристика
Инактивированная вакцина для профилактики гепатита A.
Состав и форма выпуска
0,5 мл суспензии для инъекции с 1 дозой инактивированной вакцины для профилактики гепатита содержат вирус гепатита А (штамм GBM, культивированный на диплоидных клетках человека — MRC5, инактивированный формальдегидом) — 160 антигенных единиц (содержание антигена выражено с использованием внутреннего референс-стандарта); в шприцах по 1 дозе (0,5 мл), в картонной коробке 1 шприц.
Фармакологическое действие
Формирует активный специфический иммунитет к вирусу гепатита A.
Клиническая фармакология
Вакцинация, проведенная в инкубационный период заболевания гепатитом A, может оказаться неэффективной, и состояние иммунодефицита может стать причиной слабого иммунного ответа. Вакцинация препаратом не предотвращает вирусные гепатиты иной этиологии и инфекции, вызываемые др. гепатотропными микроорганизмами.
Показания
Профилактика инфекции, вызываемой вирусом гепатита A у лиц от 2 лет и старше из различных групп риска: неиммунизированных, выезжающих в эндемичные районы (с высоким уровнем заболеваемости гепатитом A), подверженных профессиональному риску заражения (персонал по уходу за больными, канализационных и водопроводных служб, работники пищевой промышленности, предприятий питания), включая особые группы риска (больные с гемофилией или с множественными гемотрансфузиями, наркоманы, гомосексуалисты).
Противопоказания
Гиперчувствительность (в т.ч. к формальдегиду), повышенная температура тела, острые или хронические прогрессирующие заболевания (в этих случаях вакцинацию желательно отложить до нормализации состояния).
Способ применения и дозы
В/м (рекомендуется введение в дельтовидную мышцу плеча), п/к (рекомендуется введение больным с тромбоцитопенией или с кровотечениями); в обычной дозе — по 0,5 мл (для каждого введения). Первичную вакцинацию производят однократным введением одной дозы вакцины; ревакцинацию проводят через 6 мес.
Применение при беременности и кормлении грудью
Нет данных о действии вакцины на эмбрион, плод и грудного ребенка. Решение о вакцинации во время беременности или лактации необходимо принимать только на основании оценки реальной опасности заражения гепатитом A.
Взаимодействие
Эффект ослабляет иммуносупрессивная терапия. Вакцина совместима с иммуноглобулинами при условии использования различной локализации для инъекций.
Меры предосторожности
Нельзя смешивать с др. вакцинами в одном шприце. С осторожностью используют препарат у пациентов с заболеваниями печени. Избегать в/в введения (необходимо убедиться, что игла не попала в кровеносный сосуд), в ягодичные мышцы (из-за вариабельности толщины жирового слоя) или в/к (возможно снижение иммунного ответа). В затруднительных случаях рекомендуется консультация врача — специалиста. Запрещено использовать вакцину после истечения срока годности.
Побочные действия
Боль и покраснение, очень редко — уплотнение в месте введения; умеренное повышение температуры тела; слабость, головная боль, боли в мышцах и суставах; диспептические расстройства, незначительное (обратимое) повышение активности печеночных трансаминаз.